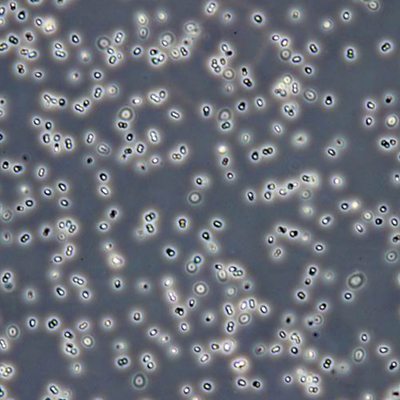

Episode details

Available for over a year
Nasa astrobiologist Lynn Rothschild describes a self-regenerating bacterium. Photo: Deniococcus bacterium Credit: Dr. Ivan Glaucio Paulino-Lima
Programme WebsiteUse ÃÛÑ¿´«Ã½.com or the new ÃÛÑ¿´«Ã½ App to listen to ÃÛÑ¿´«Ã½ podcasts, Radio 4 and the World Service outside the UK.
Available for over a year
Nasa astrobiologist Lynn Rothschild describes a self-regenerating bacterium. Photo: Deniococcus bacterium Credit: Dr. Ivan Glaucio Paulino-Lima
Programme Website